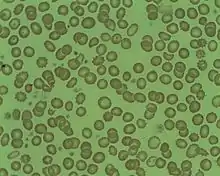

burr cell
English
blood smear showing many burr cells, namely RBCs with cytoplasmic projections which, in contrast to spur cells, are typically evenly spaced on the cell surface, more numerous (often 10 to 15 per cell), and frequently less sharp.
Noun
burr cell (plural burr cells)
- (biology, medicine) A red blood cell with abnormal appearance characterized by many small, evenly spaced thorny projections.
Synonyms
Translations
Translations
|
This article is issued from Wiktionary. The text is licensed under Creative Commons - Attribution - Sharealike. Additional terms may apply for the media files.